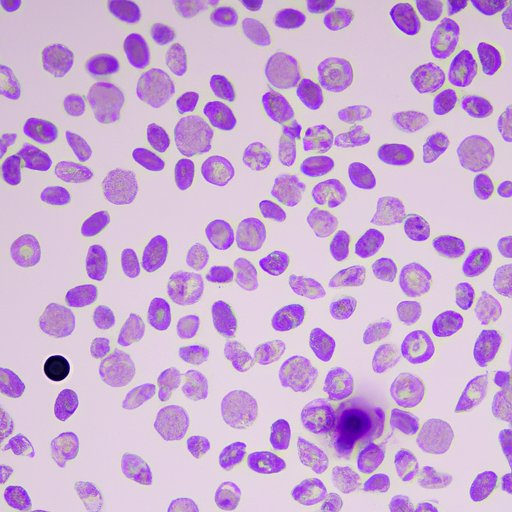

Introduction
For individuals suffering from blood disorders, understanding the significance of their reticulocyte counts is crucial for an accurate diagnosis and effective treatment. Reticulocyte counts can indicate the presence of hemolytic anemia and various underlying blood conditions. Through this article, we will explore the link between elevated reticulocyte counts and blood disorders, how they are measured, what they mean, and how they can be used for early detection and treatment.
Uncovering the Link: Elevated Reticulocyte Counts and Hemolytic Anemia
Hemolytic anemia is a condition where red blood cells are destroyed faster than they can be produced. This leads to a deficiency in red blood cells, reduced oxygen transport, and other health complications. Elevated reticulocyte counts are linked with hemolytic anemia. These young, immature red blood cells are produced by the bone marrow in response to anemia, and their presence in the blood system illustrates the bone marrow’s healthy response to a loss of red blood cells.

What Your Reticulocyte Count is Trying to Tell You
Reticulocytes are immature red blood cells that have only partially matured in the bone marrow. Reticulocyte counts are measured as a percentage of red blood cells in the bloodstream. The purpose of determining the reticulocyte count is to see how fast new red blood cells are being produced by the bone marrow.
Different levels of reticulocyte counts can indicate various conditions and diseases. Reticulocyte counts are typically higher in individuals who have undergone surgical procedures or experienced blood loss. A high reticulocyte count is also seen in individuals with hemolytic anemia and blood cancers such as leukemia and lymphoma. A low reticulocyte count may indicate bone marrow failure or iron deficiency anemia.
Elevated Reticulocyte Counts: The Key Clue in Diagnosing Blood Disorders
Elevated reticulocyte counts are an essential biomarker in diagnosing blood disorders. They can help indicate if the bone marrow is working adequately or if there is an overproduction of blood cells. If the bone marrow is not producing enough red blood cells, it can be an indicator of various health problems. This is why a blood test that includes reticulocyte counts is an essential tool for doctors to diagnose blood disorders such as anemia.
Other blood disorders associated with elevated reticulocyte counts included hemolytic crisis, sickle cell anemia, and other hemoglobinopathies.
Breaking Down the Science: How Elevated Reticulocyte Counts Point to Blood Cell Issues
Elevated reticulocyte counts are linked to blood cell issues because reticulocytes are produced by the bone marrow when the body’s demand for red blood cells is high. When an individual suffers from hemolytic anemia or other blood disorders, the production of red blood cells decreases, and the body requires more red blood cells to meet the body’s oxygen demands.
As a result, the bone marrow releases immature red blood cells into the bloodstream, increasing the reticulocyte count. The higher the reticulocyte count, the more significant the body’s need for new red blood cells. Monitoring these levels is critical in preventing complications such as organ damage and even death.
The Importance of Understanding Elevated Reticulocyte Counts in Treating Hemolytic Anemia
Understanding reticulocyte counts plays a crucial role in diagnosing and treating hemolytic anemia. Depending on the underlying cause, treatment options may vary and can include iron supplementation, folic acid, and vitamin B12, blood transfusions, or bone marrow transplants.
Through tracking reticulocyte counts, doctors can monitor the efficacy of treatments and the progress of an individual’s condition. In some instances, reticulocyte counts can even determine if a patient requires a blood transfusion, making the monitoring of these counts vital in the treatment of hemolytic anemia.
The Role of Reticulocyte Counts in Early Detection of Blood Disorders
Early detection of blood disorders can significantly improve treatment outcomes. Through reticulocyte counts, early detection of conditions such as leukemia, lymphoma, and thalassemia can occur, allowing patients to begin treatment before irreversible damage occurs.
Regular monitoring and consideration of reticulocyte counts can also help diagnose other conditions and diseases not typically associated with blood disorders, highlighting the importance of overall health management.
Elevated Reticulocyte Counts: A Predictor of Hemolytic Anemia or Underlying Blood Conditions?
Elevated reticulocyte counts do not always indicate hemolytic anemia and can be an indicator of other underlying blood conditions. Differentiating if the root cause of high reticulocyte counts is hemolytic anemia or another blood disorder is essential for proper diagnosis and treatment.
Medical professionals work to determine the cause through comprehensive medical histories, physical examinations, and targeted blood tests that may include reticulocyte counts. The treatment will ultimately depend on the underlying cause of the elevated reticulocyte count.
Conclusion
Reticulocyte counts are a vital tool in diagnosing and monitoring the treatment of blood disorders such as hemolytic anemia. Elevated reticulocyte counts may indicate the need for immediate medical attention, and early detection of blood disorders can significantly improve the outcome of treatments. Understanding the significance of elevated reticulocyte counts can help prevent severe complications and ensure proper management of an individual’s health.
If you have any concerns regarding an elevated reticulocyte count, seek medical attention promptly to determine the underlying cause.